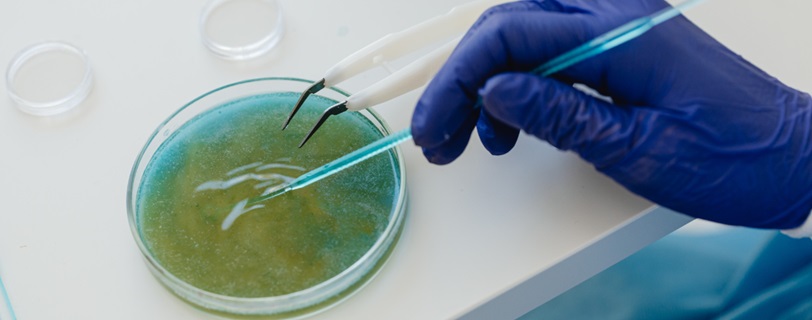

La ciencia ha dado un paso inesperado con el descubrimiento de una bacteria capaz de conducir electricidad. Más allá del asombro científico, surgen interrogantes sobre sus aplicaciones reales, implicaciones en la sostenibilidad y el futuro de los sistemas eléctricos actuales.
En este artículo desglosamos las claves de esta sorprendente innovación y su posible impacto en el panorama tecnológico y medioambiental.
Un hallazgo microscópico con un potencial colosal
El descubrimiento fue realizado por científicos de la Universidad Estatal de Oregón, en Estados Unidos, quienes estudiaban bacterias presentes en la bahía de Yaquina. Allí encontraron la bacteria bautizada como Candidatus Electrothrix yaqonensis, perteneciente a la familia de las cable bacteria, capaz de generar y conducir corriente eléctrica a través de filamentos biológicos. Este fenómeno abre una vía completamente nueva en el desarrollo de sistemas de energía basados en procesos naturales.
Según los investigadores, esta bacteria no solo genera electrones, sino que los transfiere eficientemente a lo largo de estructuras similares a cables, lo que representa una capacidad de transmisión comparable, en ciertas condiciones, a la de algunos materiales semiconductores.
Además de su capacidad de autoconducción, Electrothrix yaqonensis también presenta la ventaja de ser biodegradables y de ser eficiente en condiciones variables. Esto podría permitir su uso en dispositivos electrónicos basados en materia viva o en regiones donde otras fuentes de energía no son viables.
Aunque se encuentra en fases iniciales, el hallazgo podría traducirse en el desarrollo de:
<Biosensores ambientales capaces de monitorear la contaminación.
<Circuitos biológicos integrados en tejidos vivos.
<Soluciones con implicaciones directas en la eficiencia energética y la reducción de la huella de carbono.
<Solucionar problemas de conexión o de cortes de luz sin cables.
Un futuro energético más orgánico y sostenible
En un mundo que busca con urgencia alternativas limpias y sostenibles, este avance ofrece una ventana hacia formas de producción energética menos invasivas. A diferencia de los materiales sintéticos que requieren procesos industriales complejos y costosos, el uso de bacterias como conductores eléctricos podría reducir notablemente el impacto ambiental de la industria energética.
Uno de los usos más prometedores de este descubrimiento se sitúa en el ámbito de las pilas microbianas. En estos sistemas, los microorganismos generan electricidad a partir de la descomposición de materia orgánica, y ahora, con bacterias conductoras, se abre la posibilidad de mejorar su eficiencia y autonomía. Este tipo de tecnologías son especialmente útiles en zonas rurales, sitios aislados o con acceso limitado a infraestructuras energéticas convencionalmente gestionadas por las distribuidoras de luz y gas.
Obstáculos y desafíos para una revolución eléctrica bacteriana
A pesar del entusiasmo que genera este hallazgo, los científicos reconocen que el camino hacia su aplicación comercial está lleno de retos para las comercializadoras energéticas. Uno de los principales obstáculos es la estabilidad y durabilidad de las bacterias en condiciones industriales.
Otro aspecto técnico que limita su uso inmediato es la intensidad de la corriente generada. Aunque estas bacterias pueden conducir electricidad, la cantidad de energía producida aún es baja en comparación con las fuentes tradicionales. Esto obliga a investigar formas de optimizar su rendimiento mediante ingeniería genética o técnicas de cultivo especializadas.
Mientras tanto, el mundo observa con atención el avance de estas investigaciones, que podrían ser clave para reducir el consumo energético de manera sostenible y eficaz.
Fuente: papernest.es
